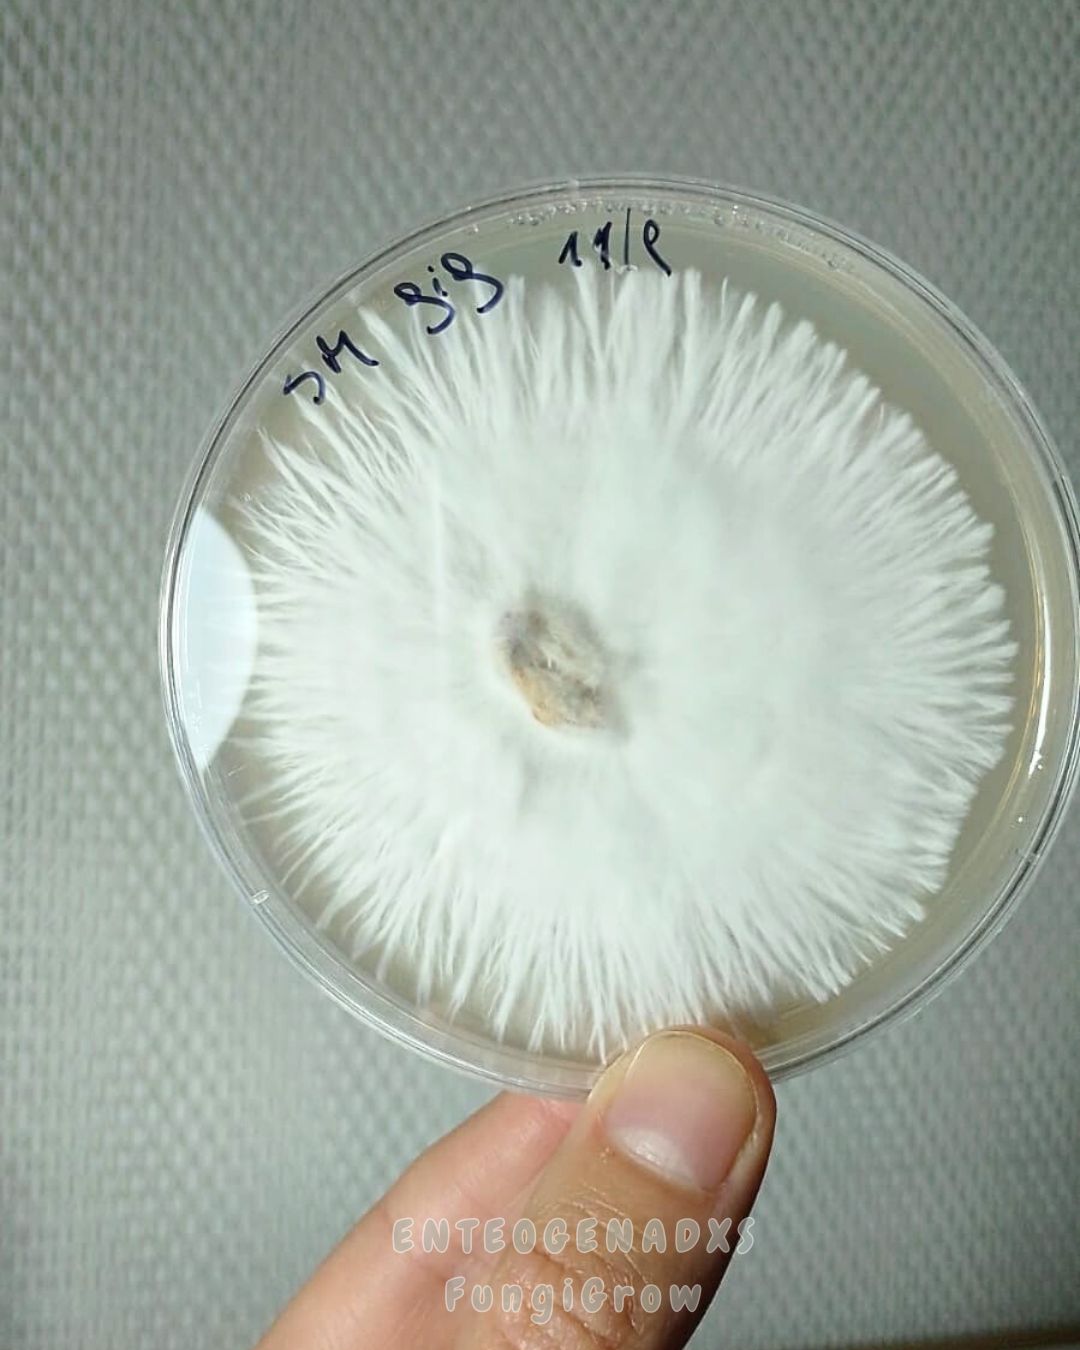

20% OFF
COMPRANDO 2 O MÁS

Placa petri: micelio en PDA. Medio nutritivo Agar agar, papa y dextroza. Colonizado y trabajado para un mejor rendimiento.
Con esta presentacion vas a poder replicar la cepa, sembrar en grano y armar tu propio honey tek (micelio en medios liquidos).
Consultar stock de cepas.